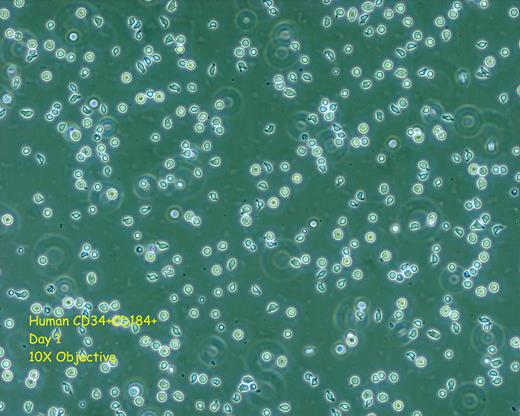
Figure 1. Human CD34+CD184+ Sorted Population

Abstract
Dendritic cells (DCs) play a central role in innate immunity and adaptive immunity. DCs are antigen presenting cells capable of inducing primary T cell responses or facilitating self-tolerance. Myeloid DCs (mDC) express CD11c. They are further divided into Type 1 myeloid DCs (mDC1) which are CD1c+CD141+ and Type 2 mDCs (mDC2) which are CD1c-CD141+, and plasmacytoid DC which are CD11c- and express CD303. Plasmacytoid DCs are the main source of type 1 interferon upon infection. CD34+ cells are a heterogeneous population of cells which contain both hematopoietic progenitors and stem cells. The microarray signature of CD34+CXCR4 (CD184)+ cells in both human and non-human primates suggest that this cell population plays a role in innate immunity. The signaling pathway for the Triggering Receptor Expressed on Myeloid Cells 1 (TREM1) is the most up-regulated pathway in both human and non-human primate sorted CD34+CD184+ cells. The TREM family is involved in the amplification and regulation of inflammatory responses. Upon sorting both human and rhesus CD34+ cells into CD34+CD184+ and CD34+CD184-, we observe that CD34+CD184+ cells are both adherent and non-adherent in nature (Figure 1) and while maintained in Flt3-L, IL-3, and SCF form progeny which appear dendritic in nature (Figure 2). In addition, we have found the CD34+CD184+ subpopulation to be resistant to lentiviral vector transduction. Upon culturing in defined, serum free media supplemented with cytokines, the progeny of the CD34+CD184+ population using both flow cytometry and confocal microscopy are CD11c+ and contain both CD1c+ and CD1c- subpopulations (Figure 3) with a predominately CD80(B7-1)+, CD123(IL-3R)+, CD197 (CCR7)+ , and HLA-Dr+ immunophenotype, having variability in CD86(B7-2) +/-, CD141(BDCA-3/Thrombomodulin)+/- , and CD144 (VE-cadherin)+/- expression, and being negative for CD303(BDCA-2)and CD309(VEGFR). Of special interest is that the CD34+CD184+ progeny contain both CD1c-CD16+ and CD1c+CD16- subpopulations of mDC. CD1c-CD16+ mDC have been shown to have strong pro-inflammatory activity, whereas CD1c+CD16- mDC are mainly inducers of chemotaxis. The progeny of the CD34+CD184+ cells can be stimulated by LPS and IFNγ to produce IL-12 based on an enzyme-linked immunosorbent assay. These results demonstrate the importance of the CD34+CXCR4+ progenitor in mDC development and allow one to speculate on how this mDC progenitor might prove of therapeutic benefit in vaccine development and cancer therapy.
Figure 1
Human CD34+CD184+ Sorted Population
Figure 2
Cultured Progeny CD34+CD184+
Figure 3
Non-Human Primate CD34+CD184+ Confocal Microscopy
Disclosures:
No relevant conflicts of interest to declare.
Author notes
*
Asterisk with author names denotes non-ASH members.
© 2013 by The American Society of Hematology
2013

This feature is available to Subscribers Only
Sign In or Create an Account Close Modal